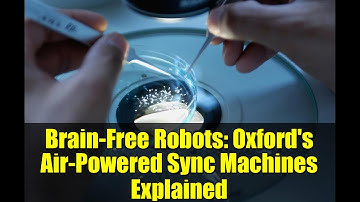
Brain-Free Robots: Oxford

⬇ DOWNLOAD NOW
Kalau muncul iklan pop-up, tutup lalu klik tombol kembali
Download lagu Oxford researchers develop air-powered robots that move in sync without electronics 🤖 secara gratis hanya untuk keperluan promosi. Dukung artis favorit kamu dengan membeli musik original di iTunes atau platform resmi lainnya.
 Air-Powered Robots That Think for Themselves
Air-Powered Robots That Think for Themselves
 Air-Powered Robots: Moving in Sync WITHOUT Electronics! | Soft Robotics Innovation
Air-Powered Robots: Moving in Sync WITHOUT Electronics! | Soft Robotics Innovation
 Brain-Free Robots! Air-Powered Bots Move in Sync Without Computers
Brain-Free Robots! Air-Powered Bots Move in Sync Without Computers
 Oxford's Air-Powered Brain-Free Robots Synchronize Without Electronics!
Oxford's Air-Powered Brain-Free Robots Synchronize Without Electronics!
 Brain-Free Robots! Air-Powered Bots Move in Sync Without Computers
Brain-Free Robots! Air-Powered Bots Move in Sync Without Computers
 Oxford's Air-Powered Brain-Free Sync Robots: No Electronics Needed!
Oxford's Air-Powered Brain-Free Sync Robots: No Electronics Needed!
 Brain-Free Robots: Air-Powered Machines That Sync Without Electronics!
Brain-Free Robots: Air-Powered Machines That Sync Without Electronics!
Brain-Free Robots: Oxford's Air-Powered Sync Machines Explained
Brain-Free Robots: Oxford's Air-Powered Sync Machines Explained